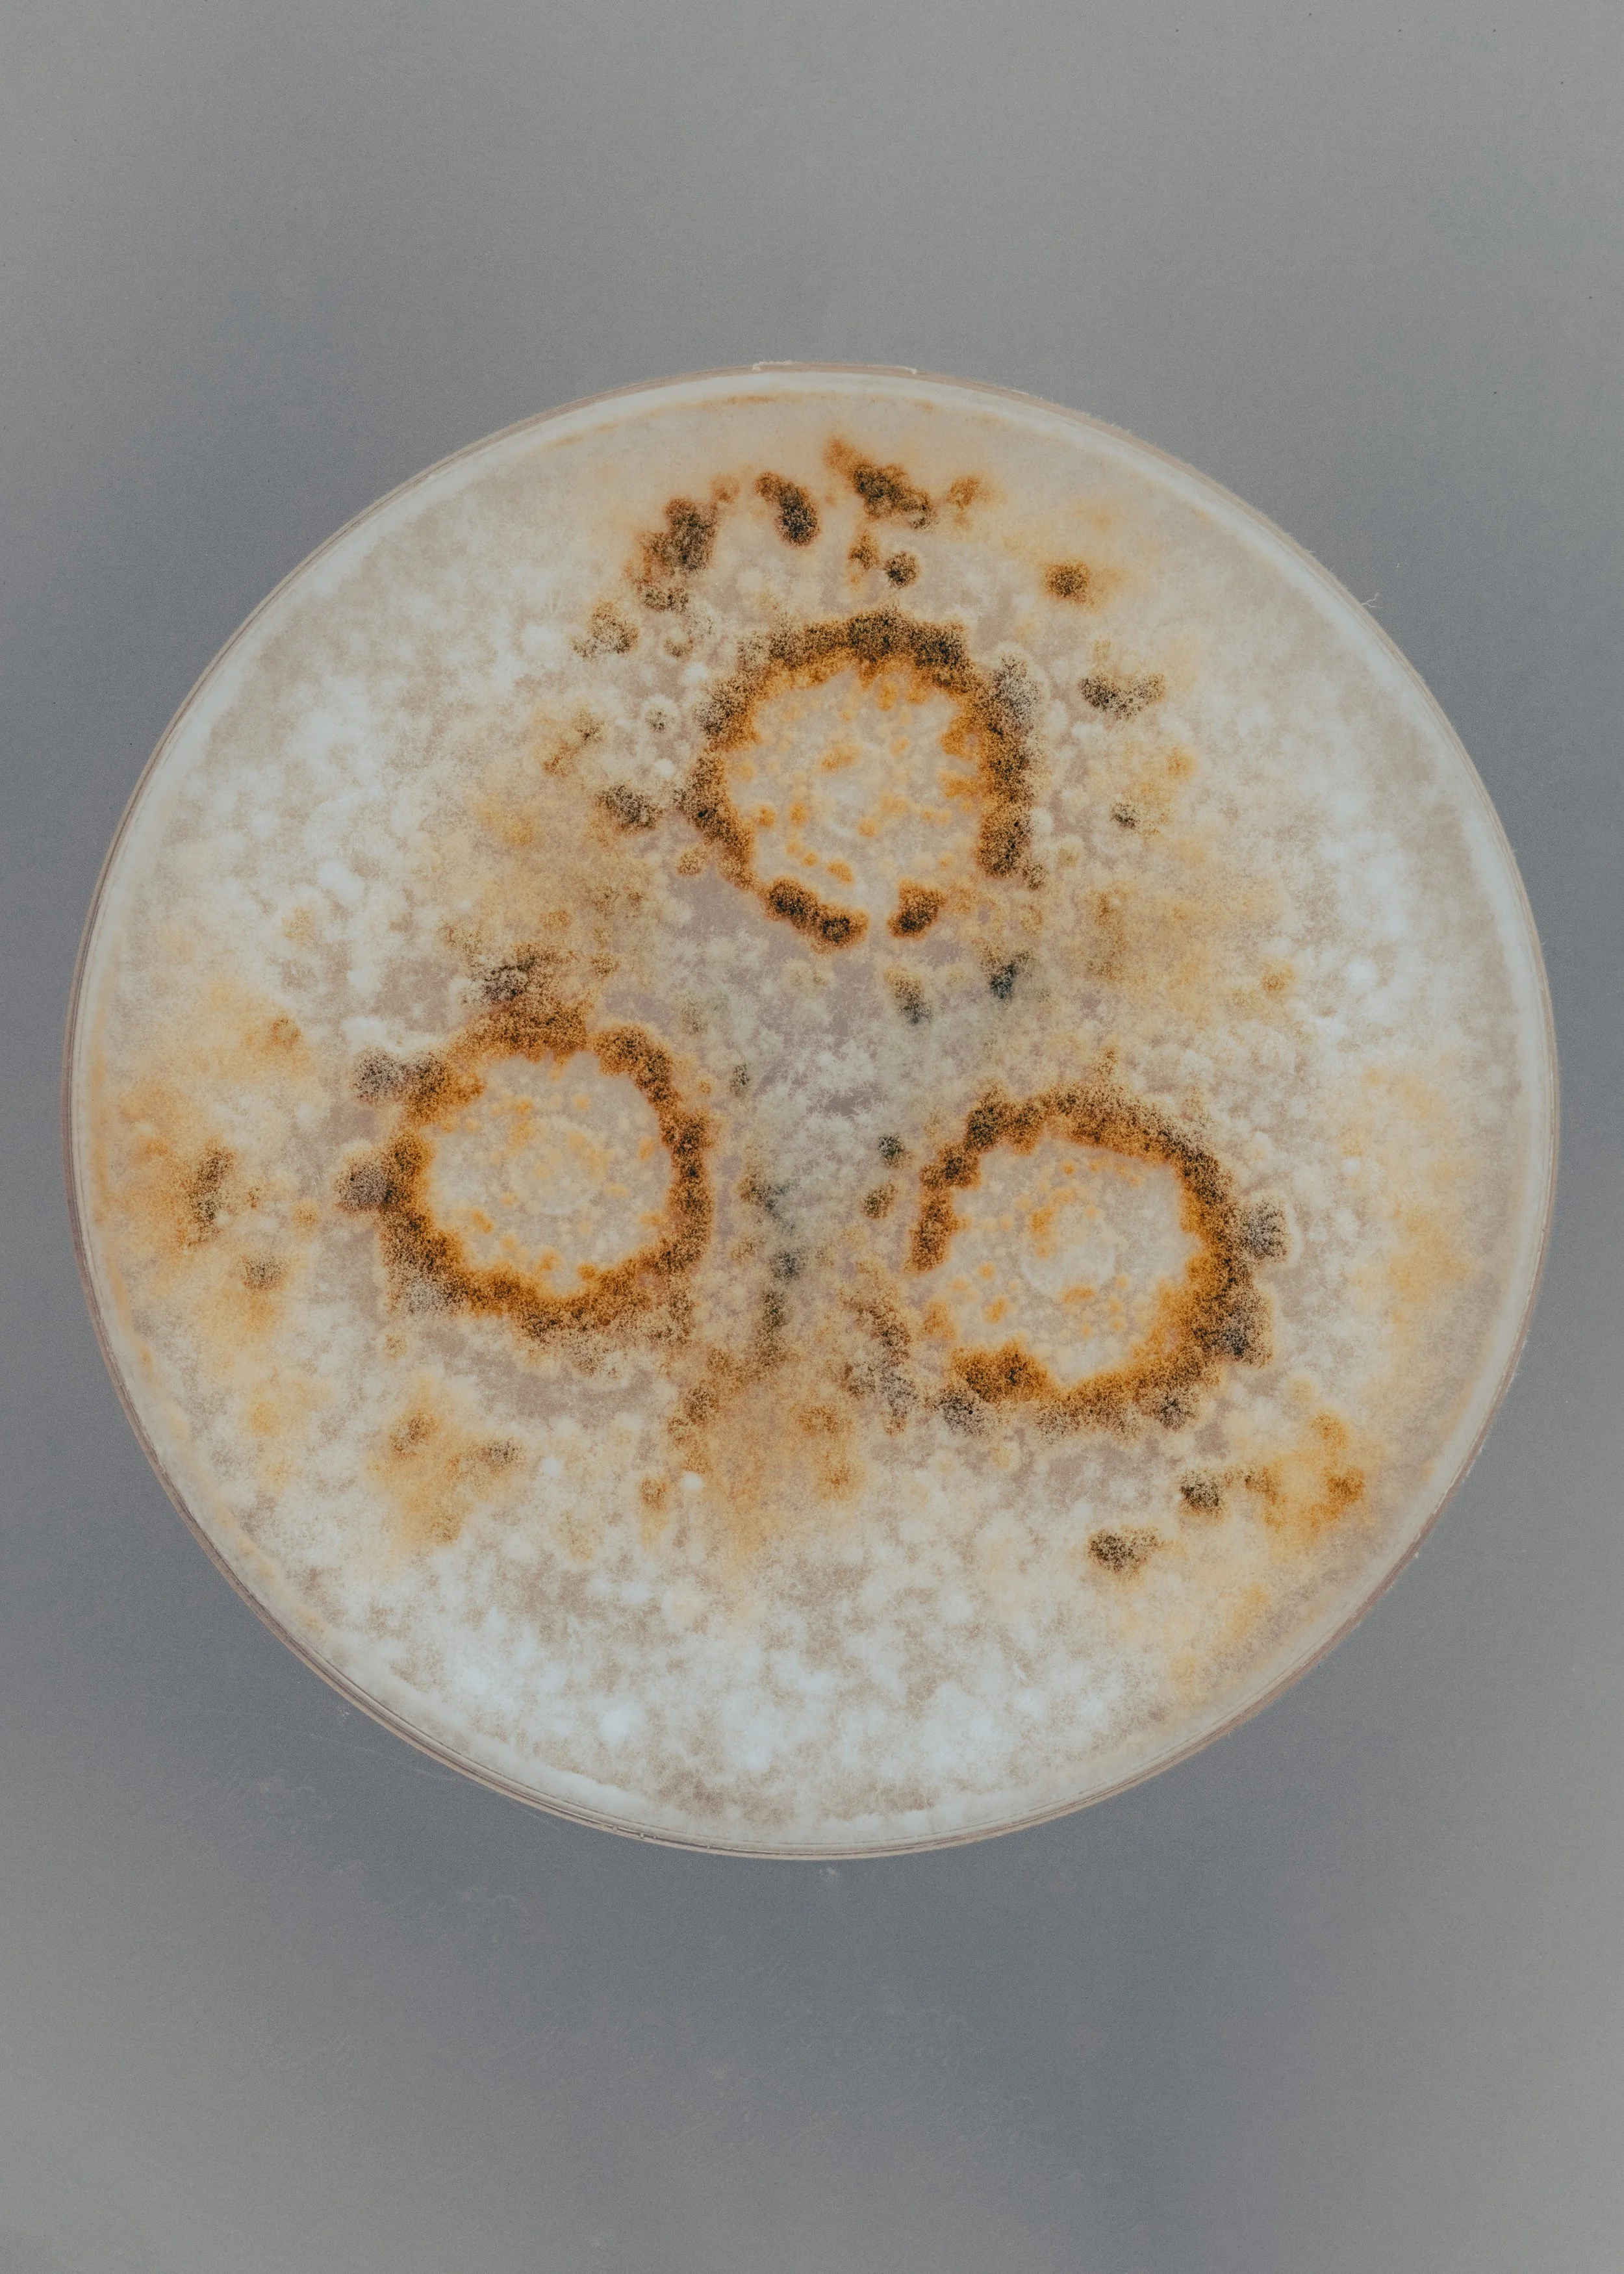
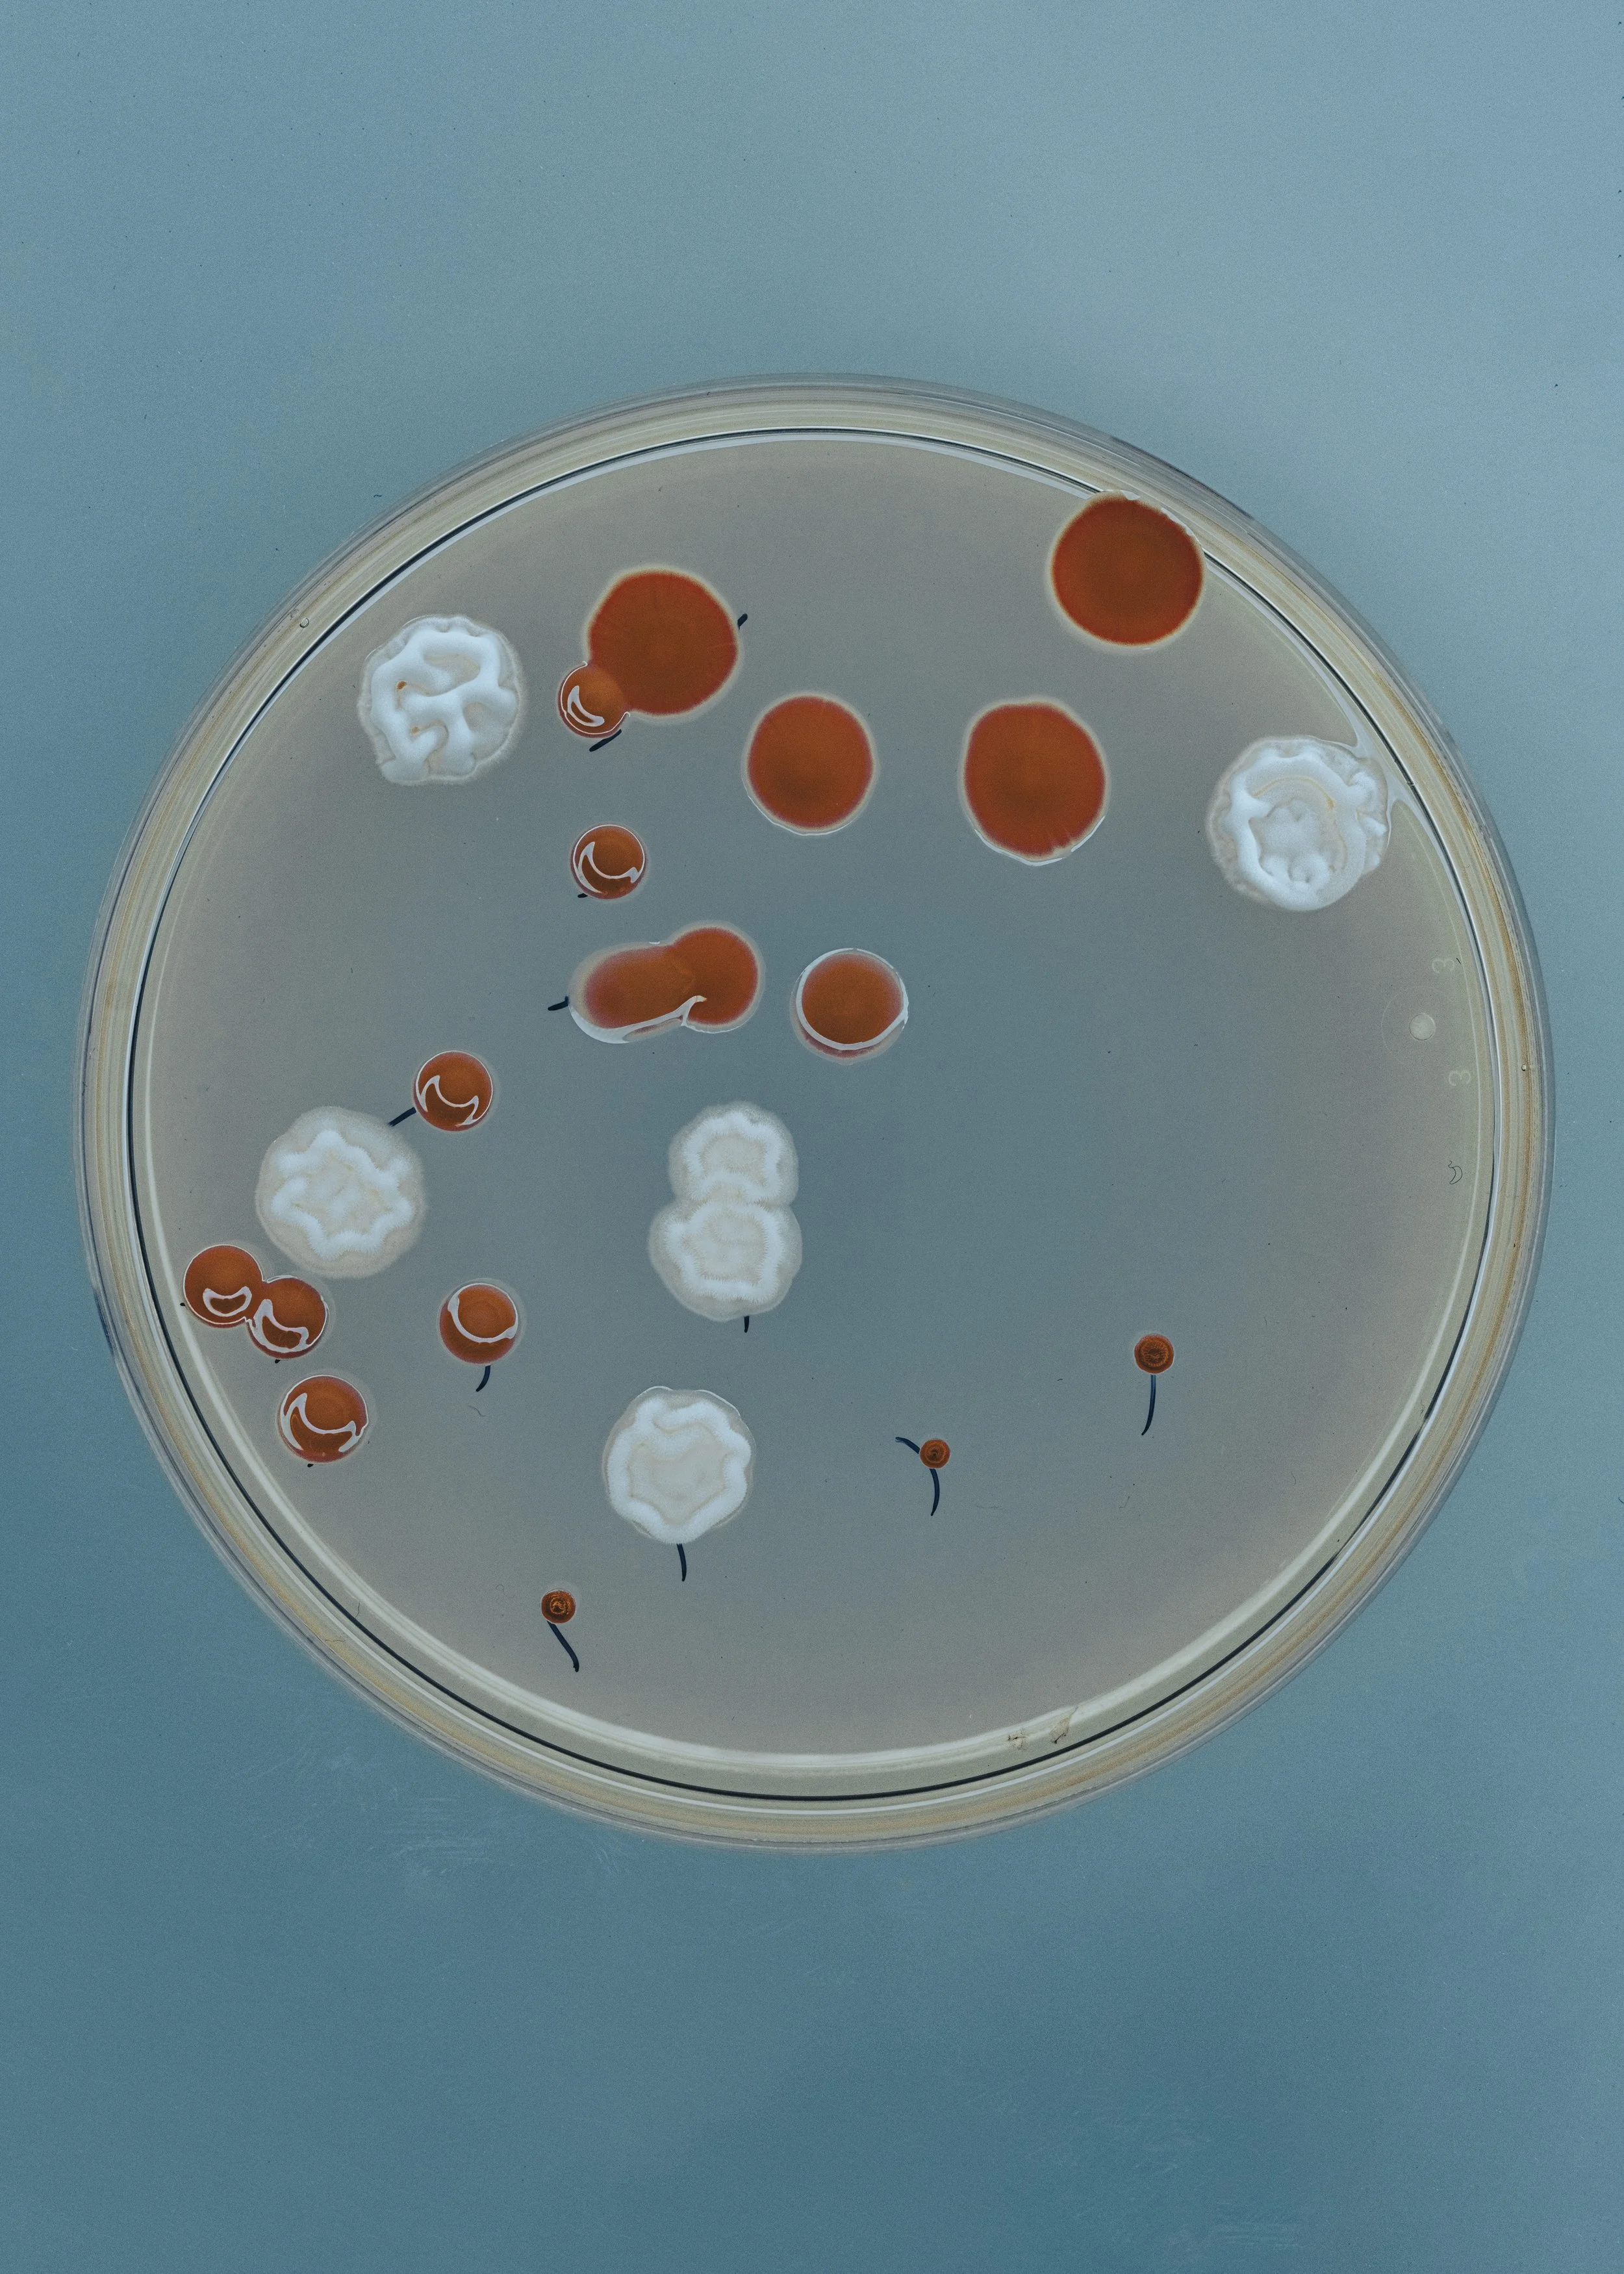
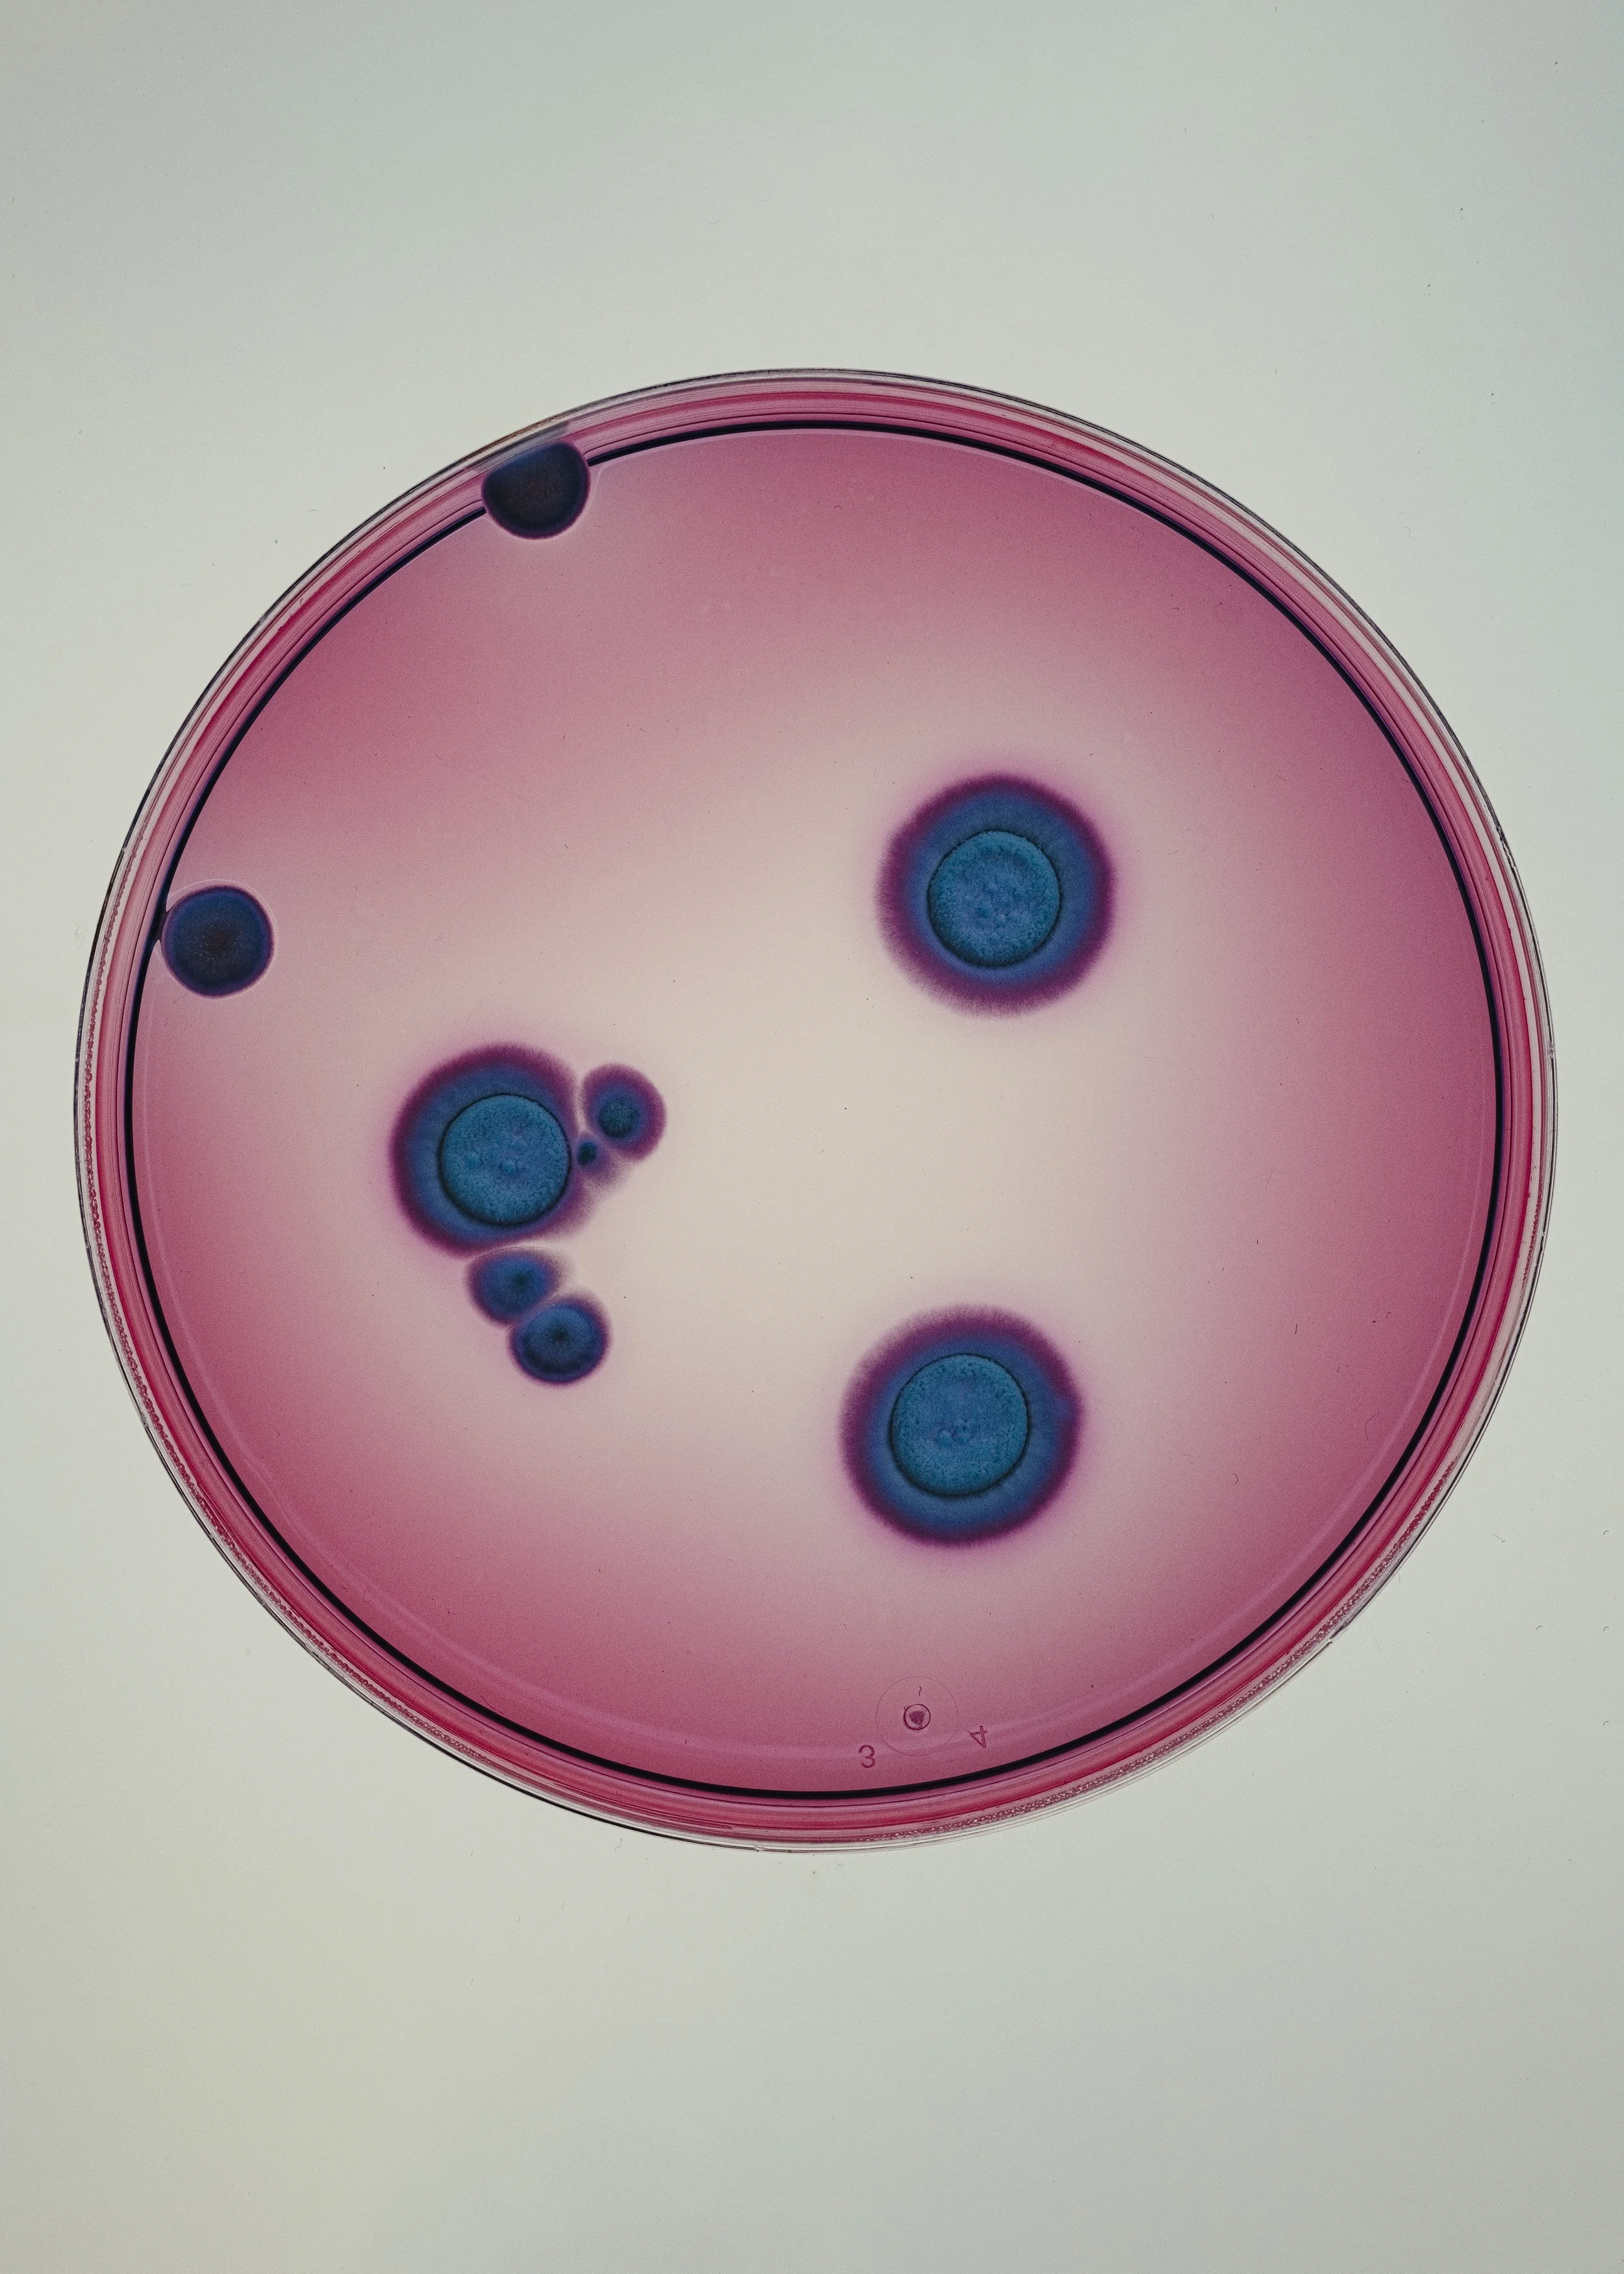
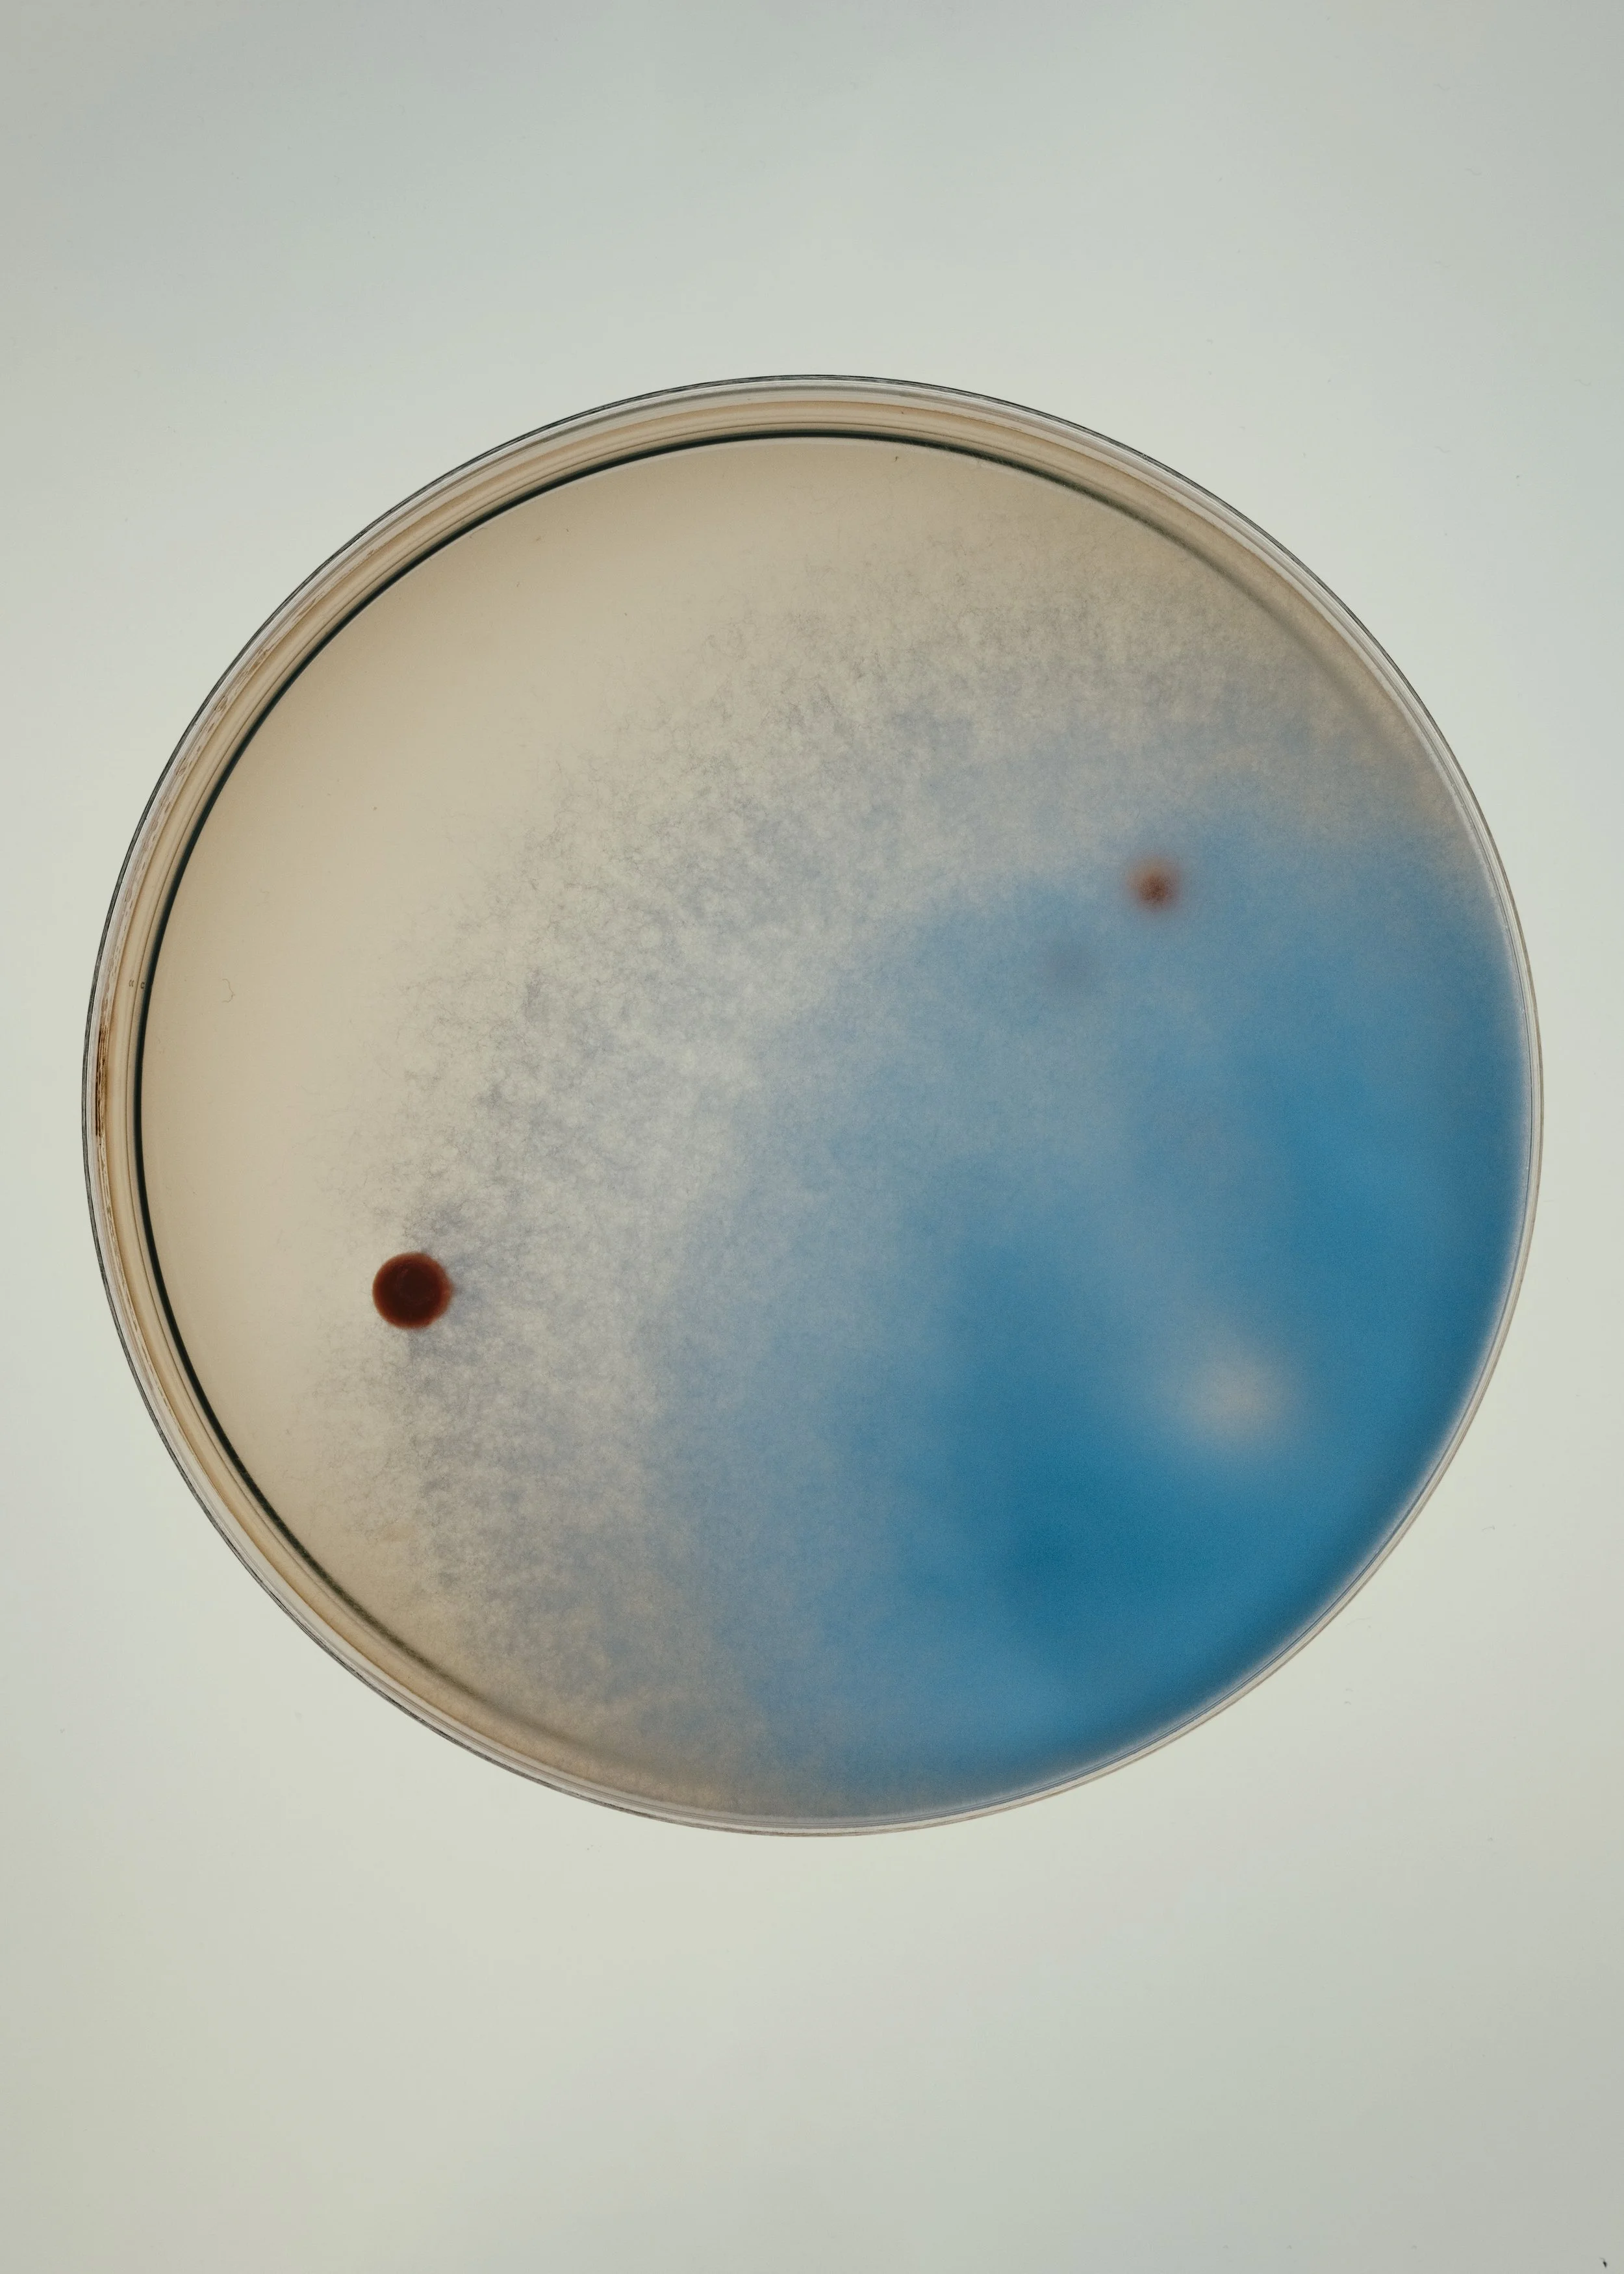
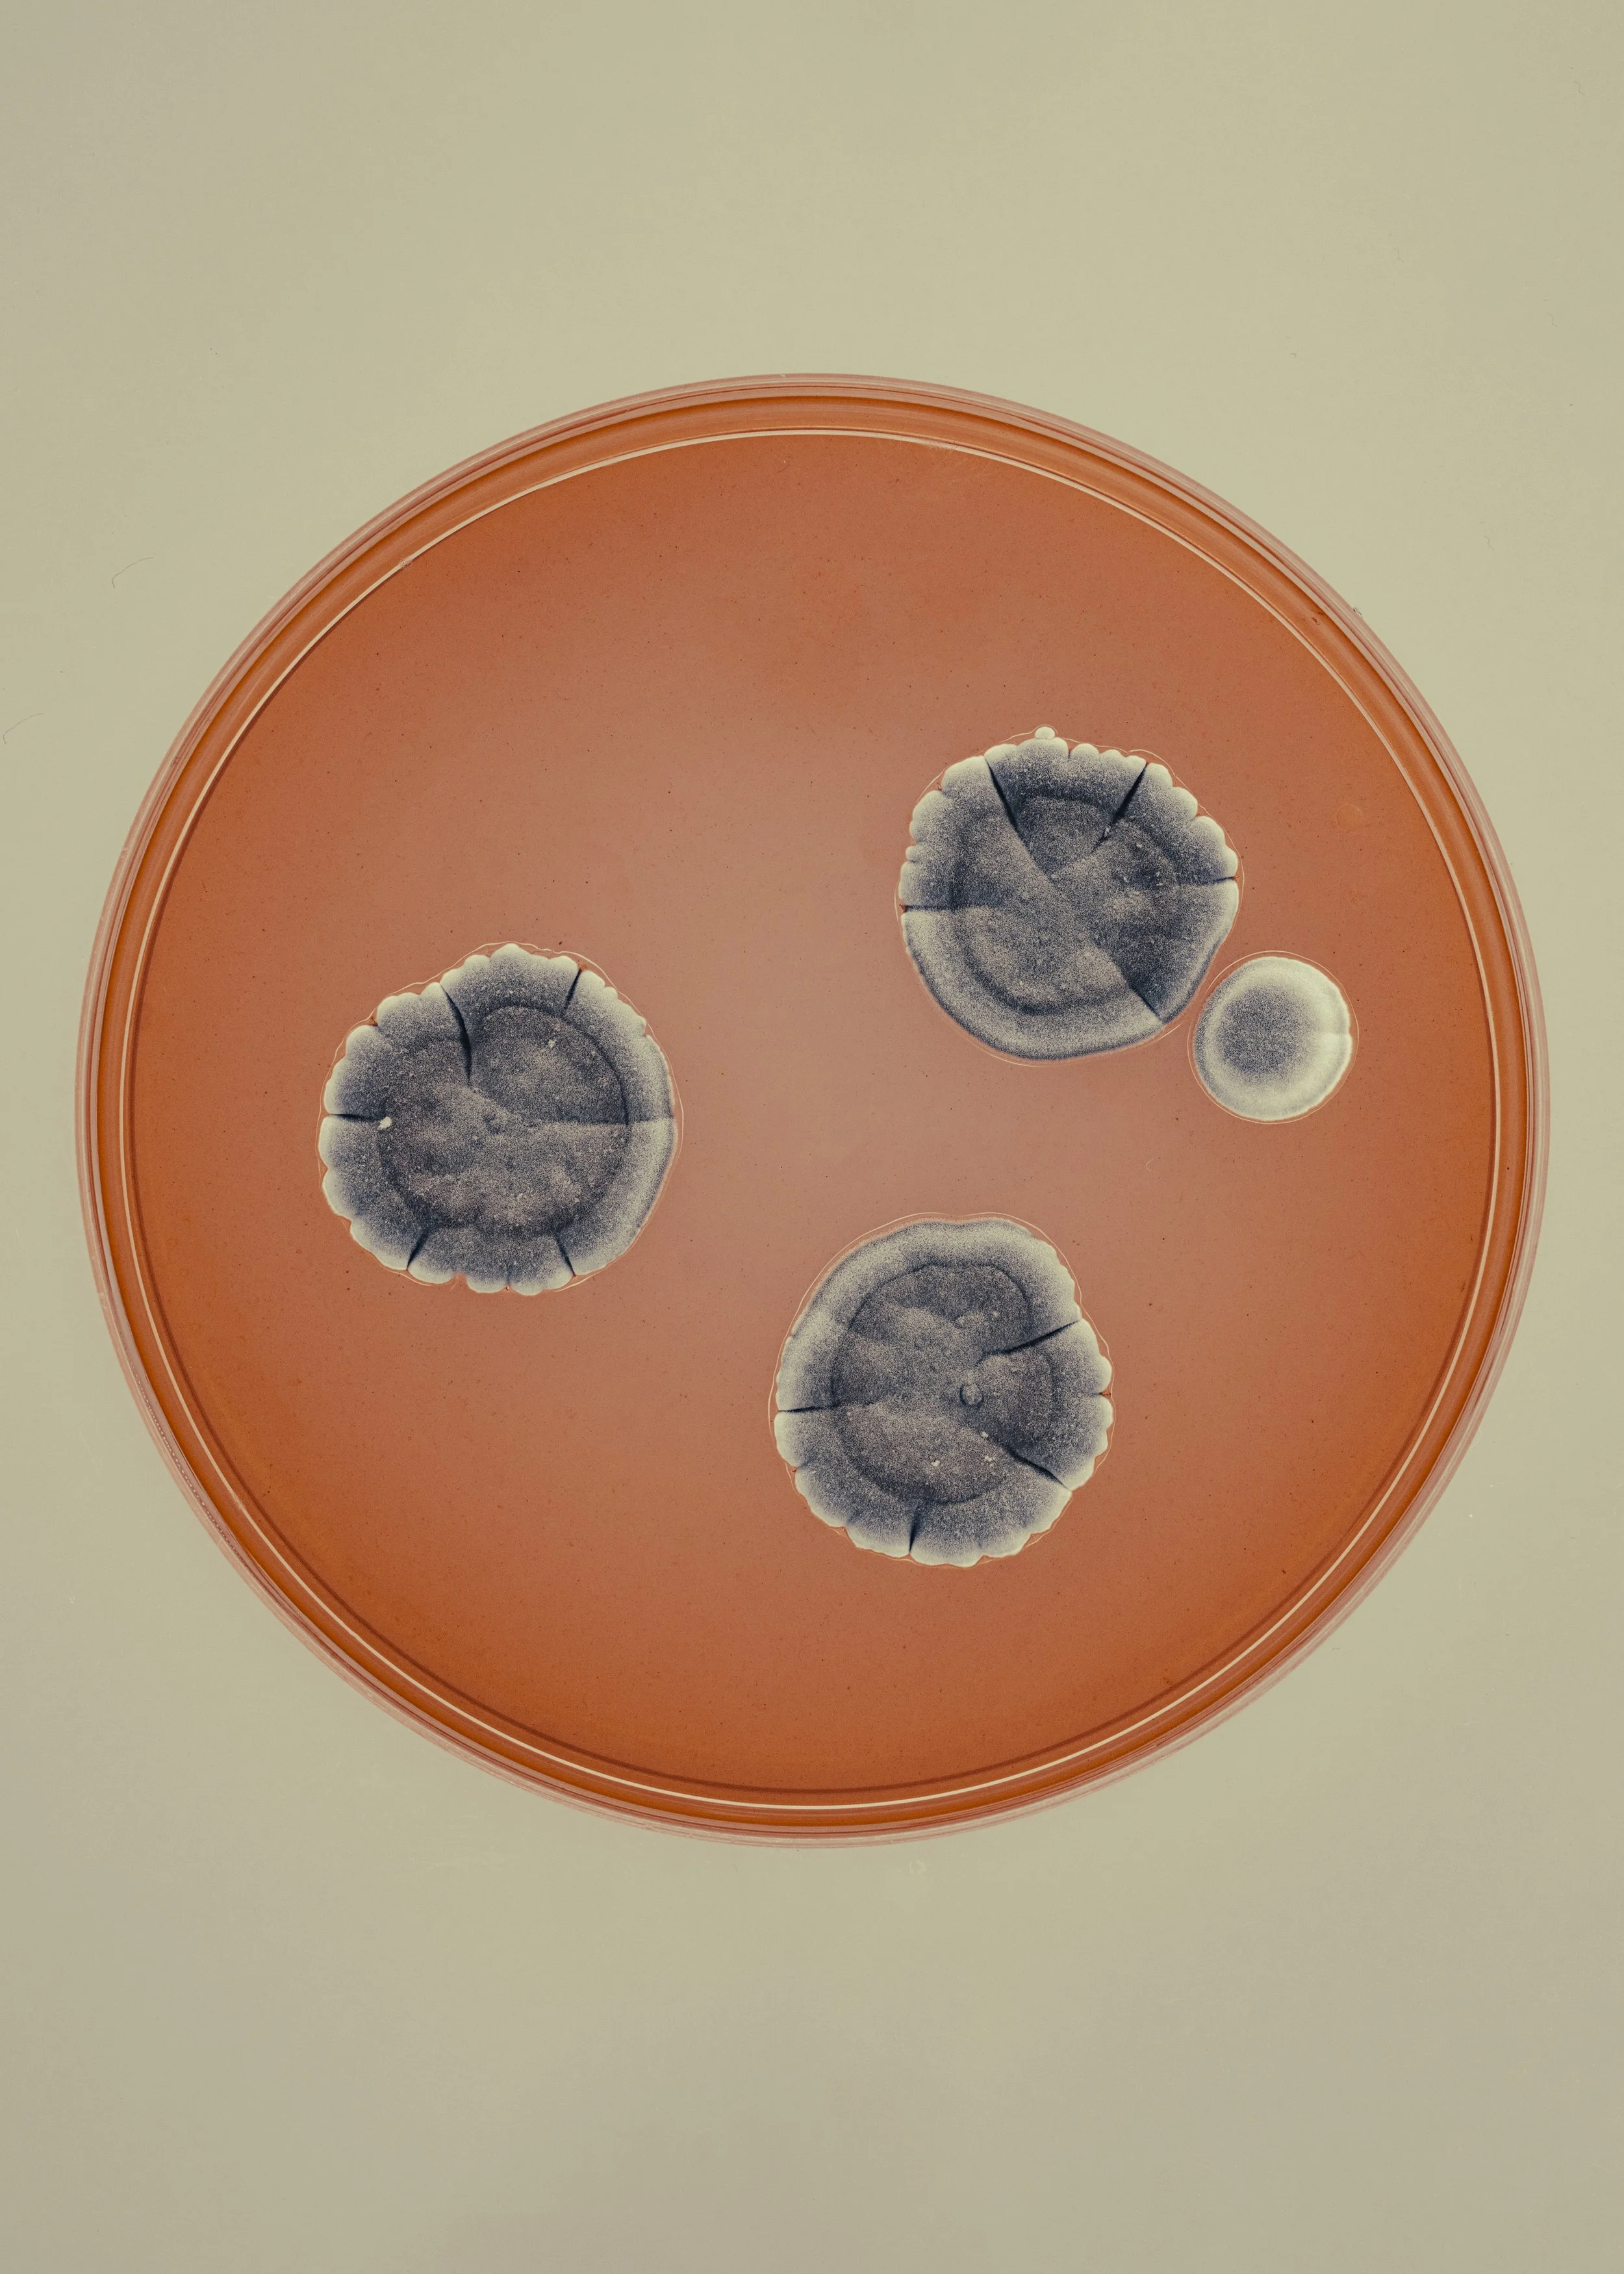
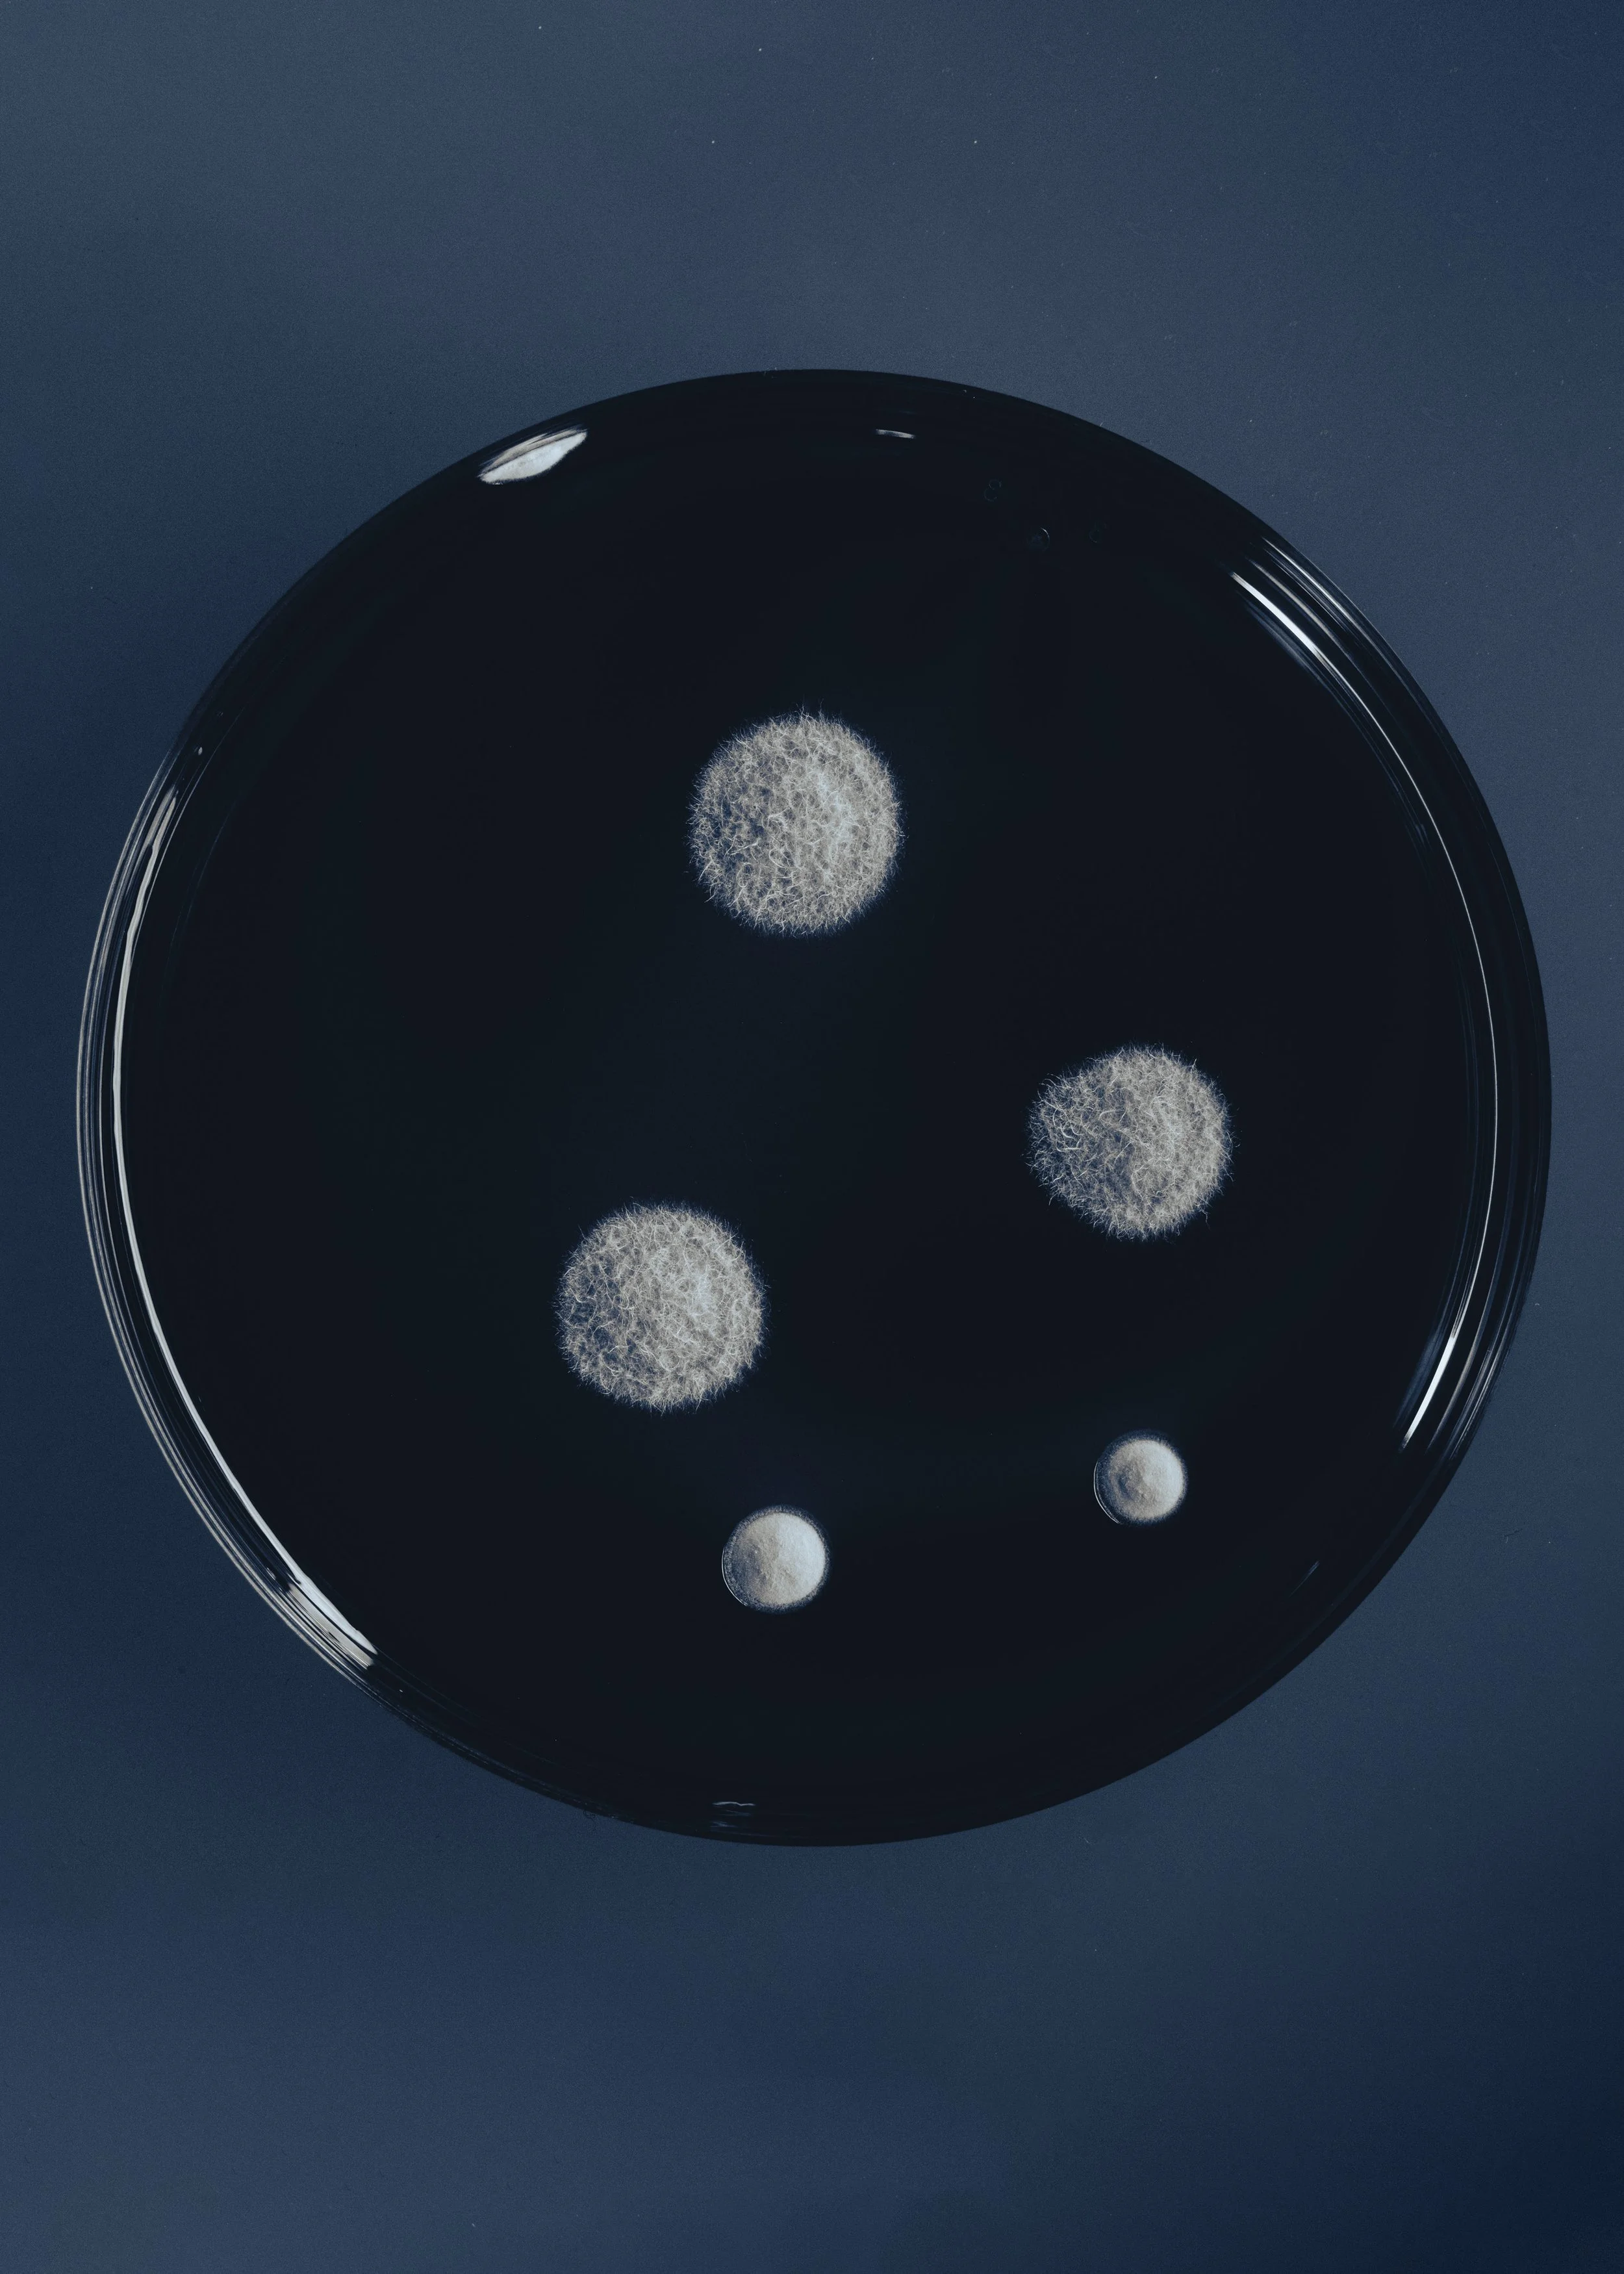
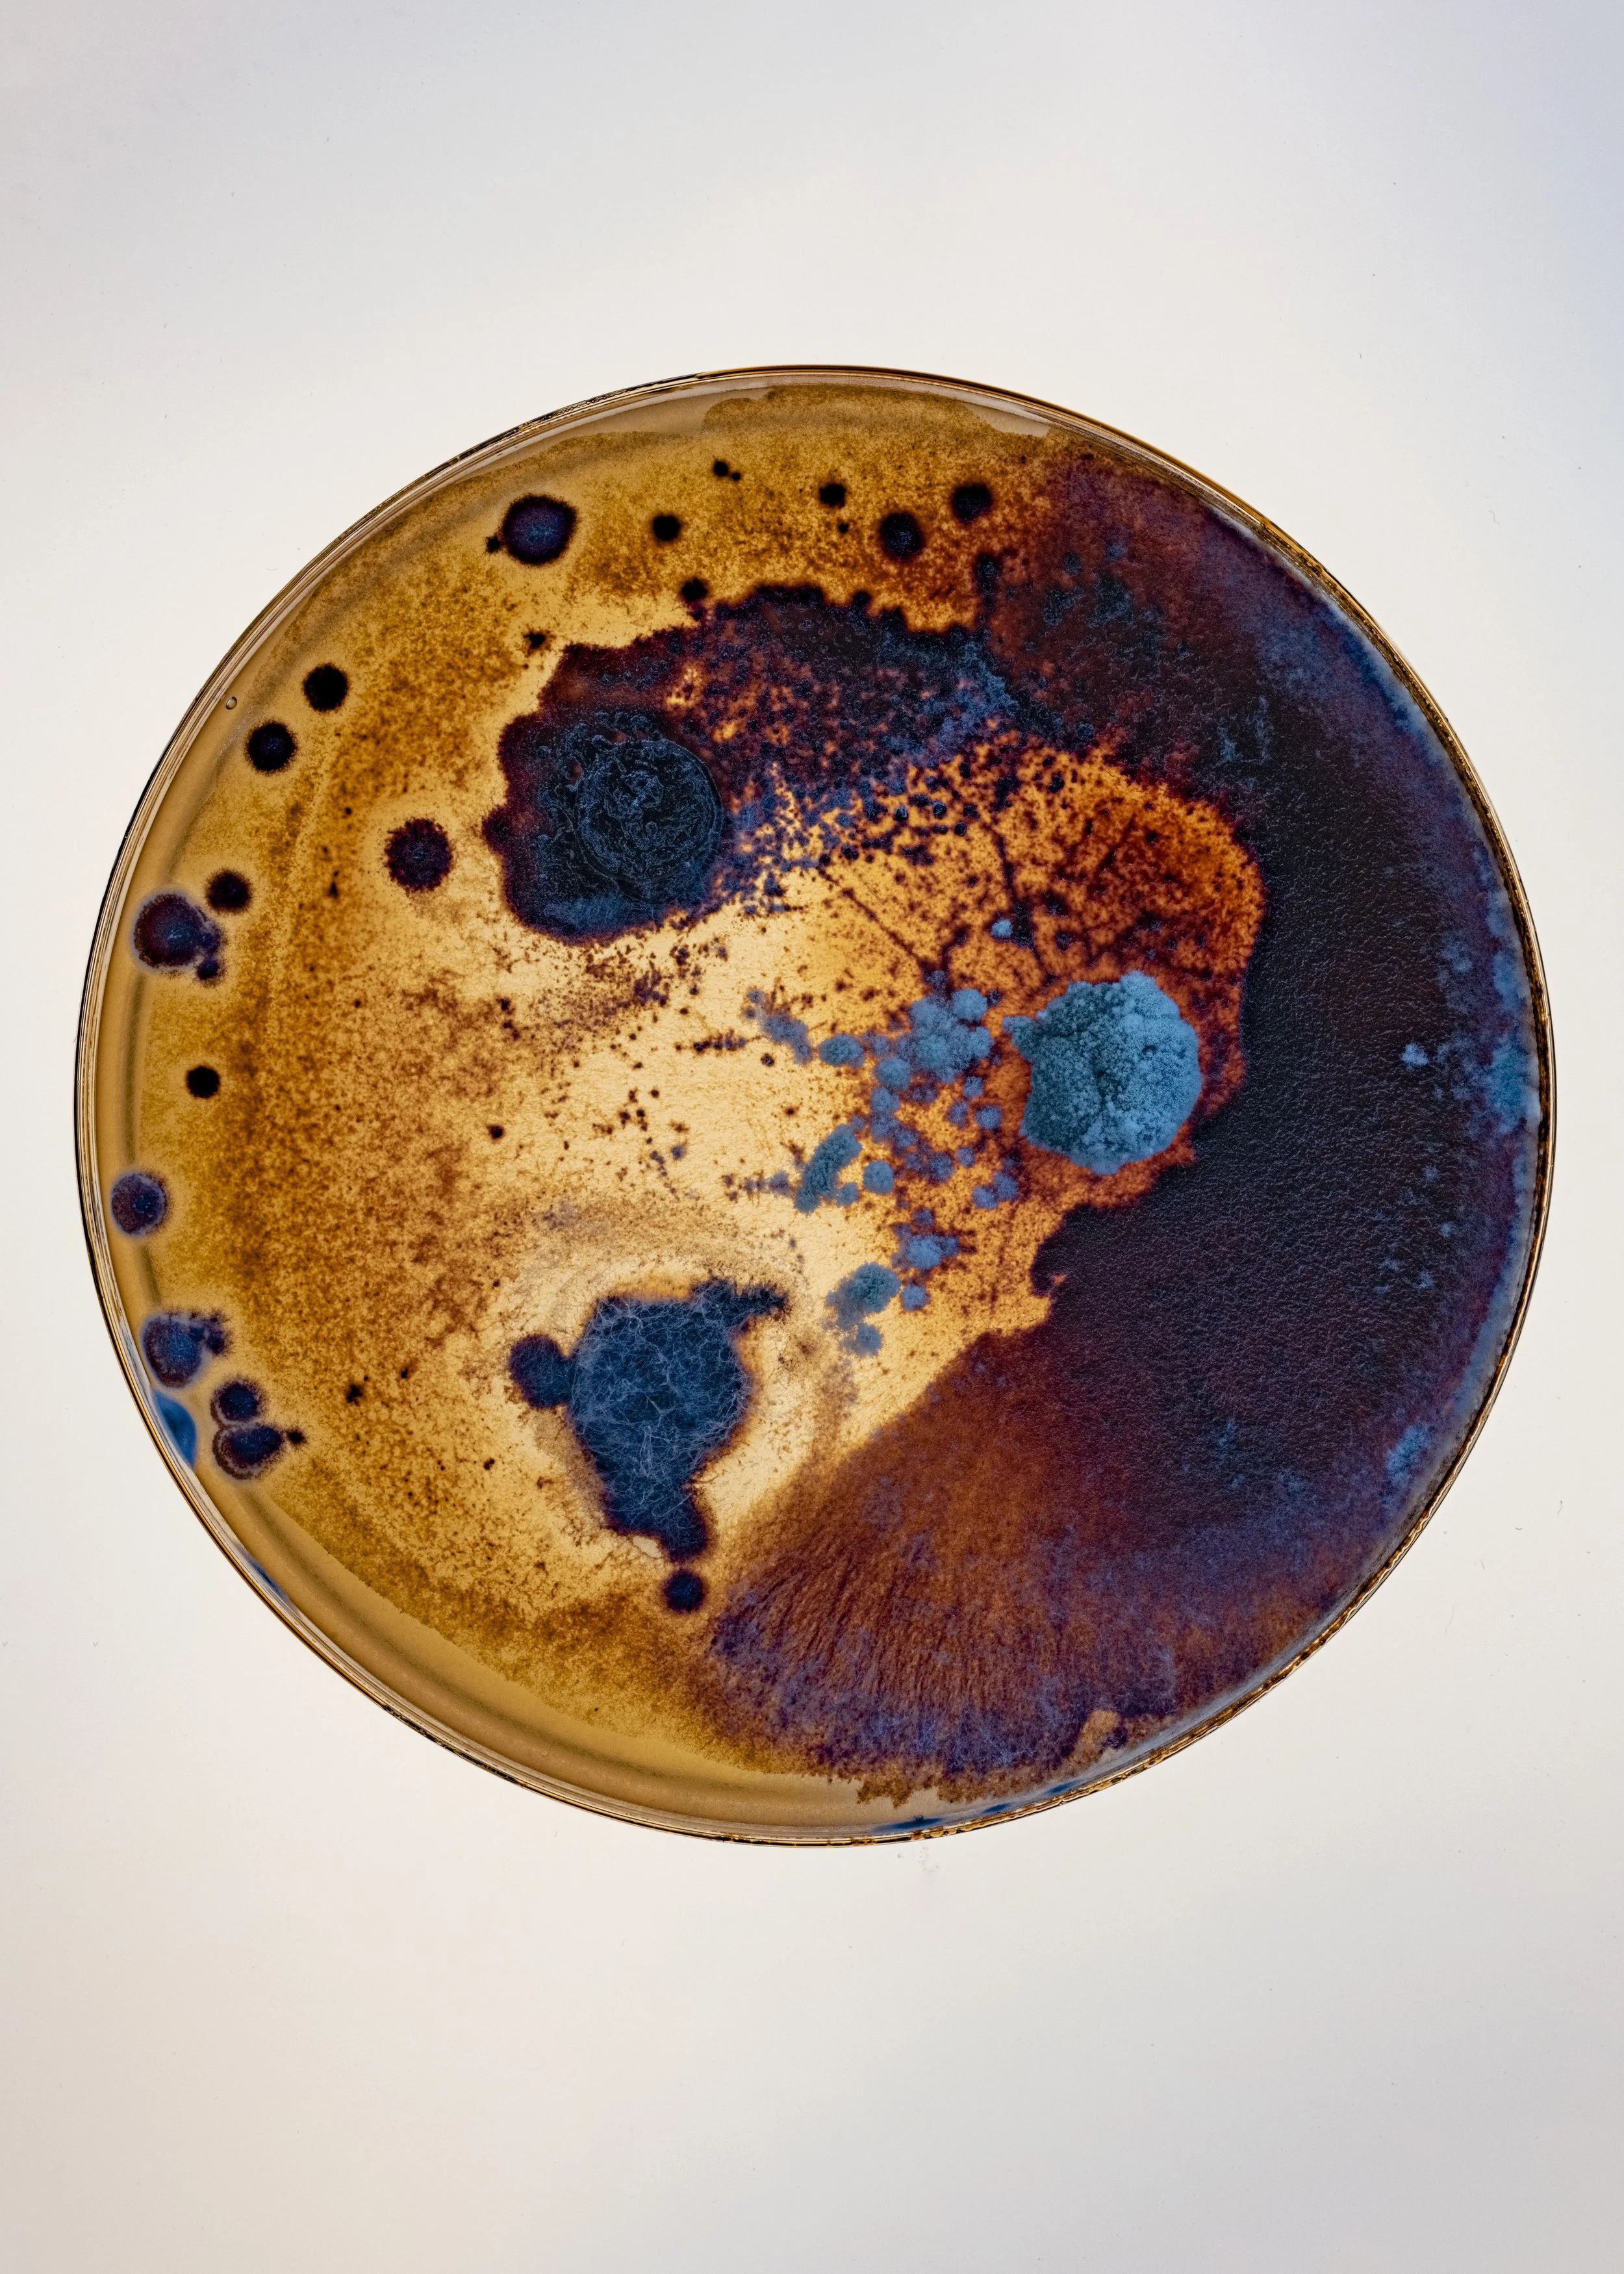
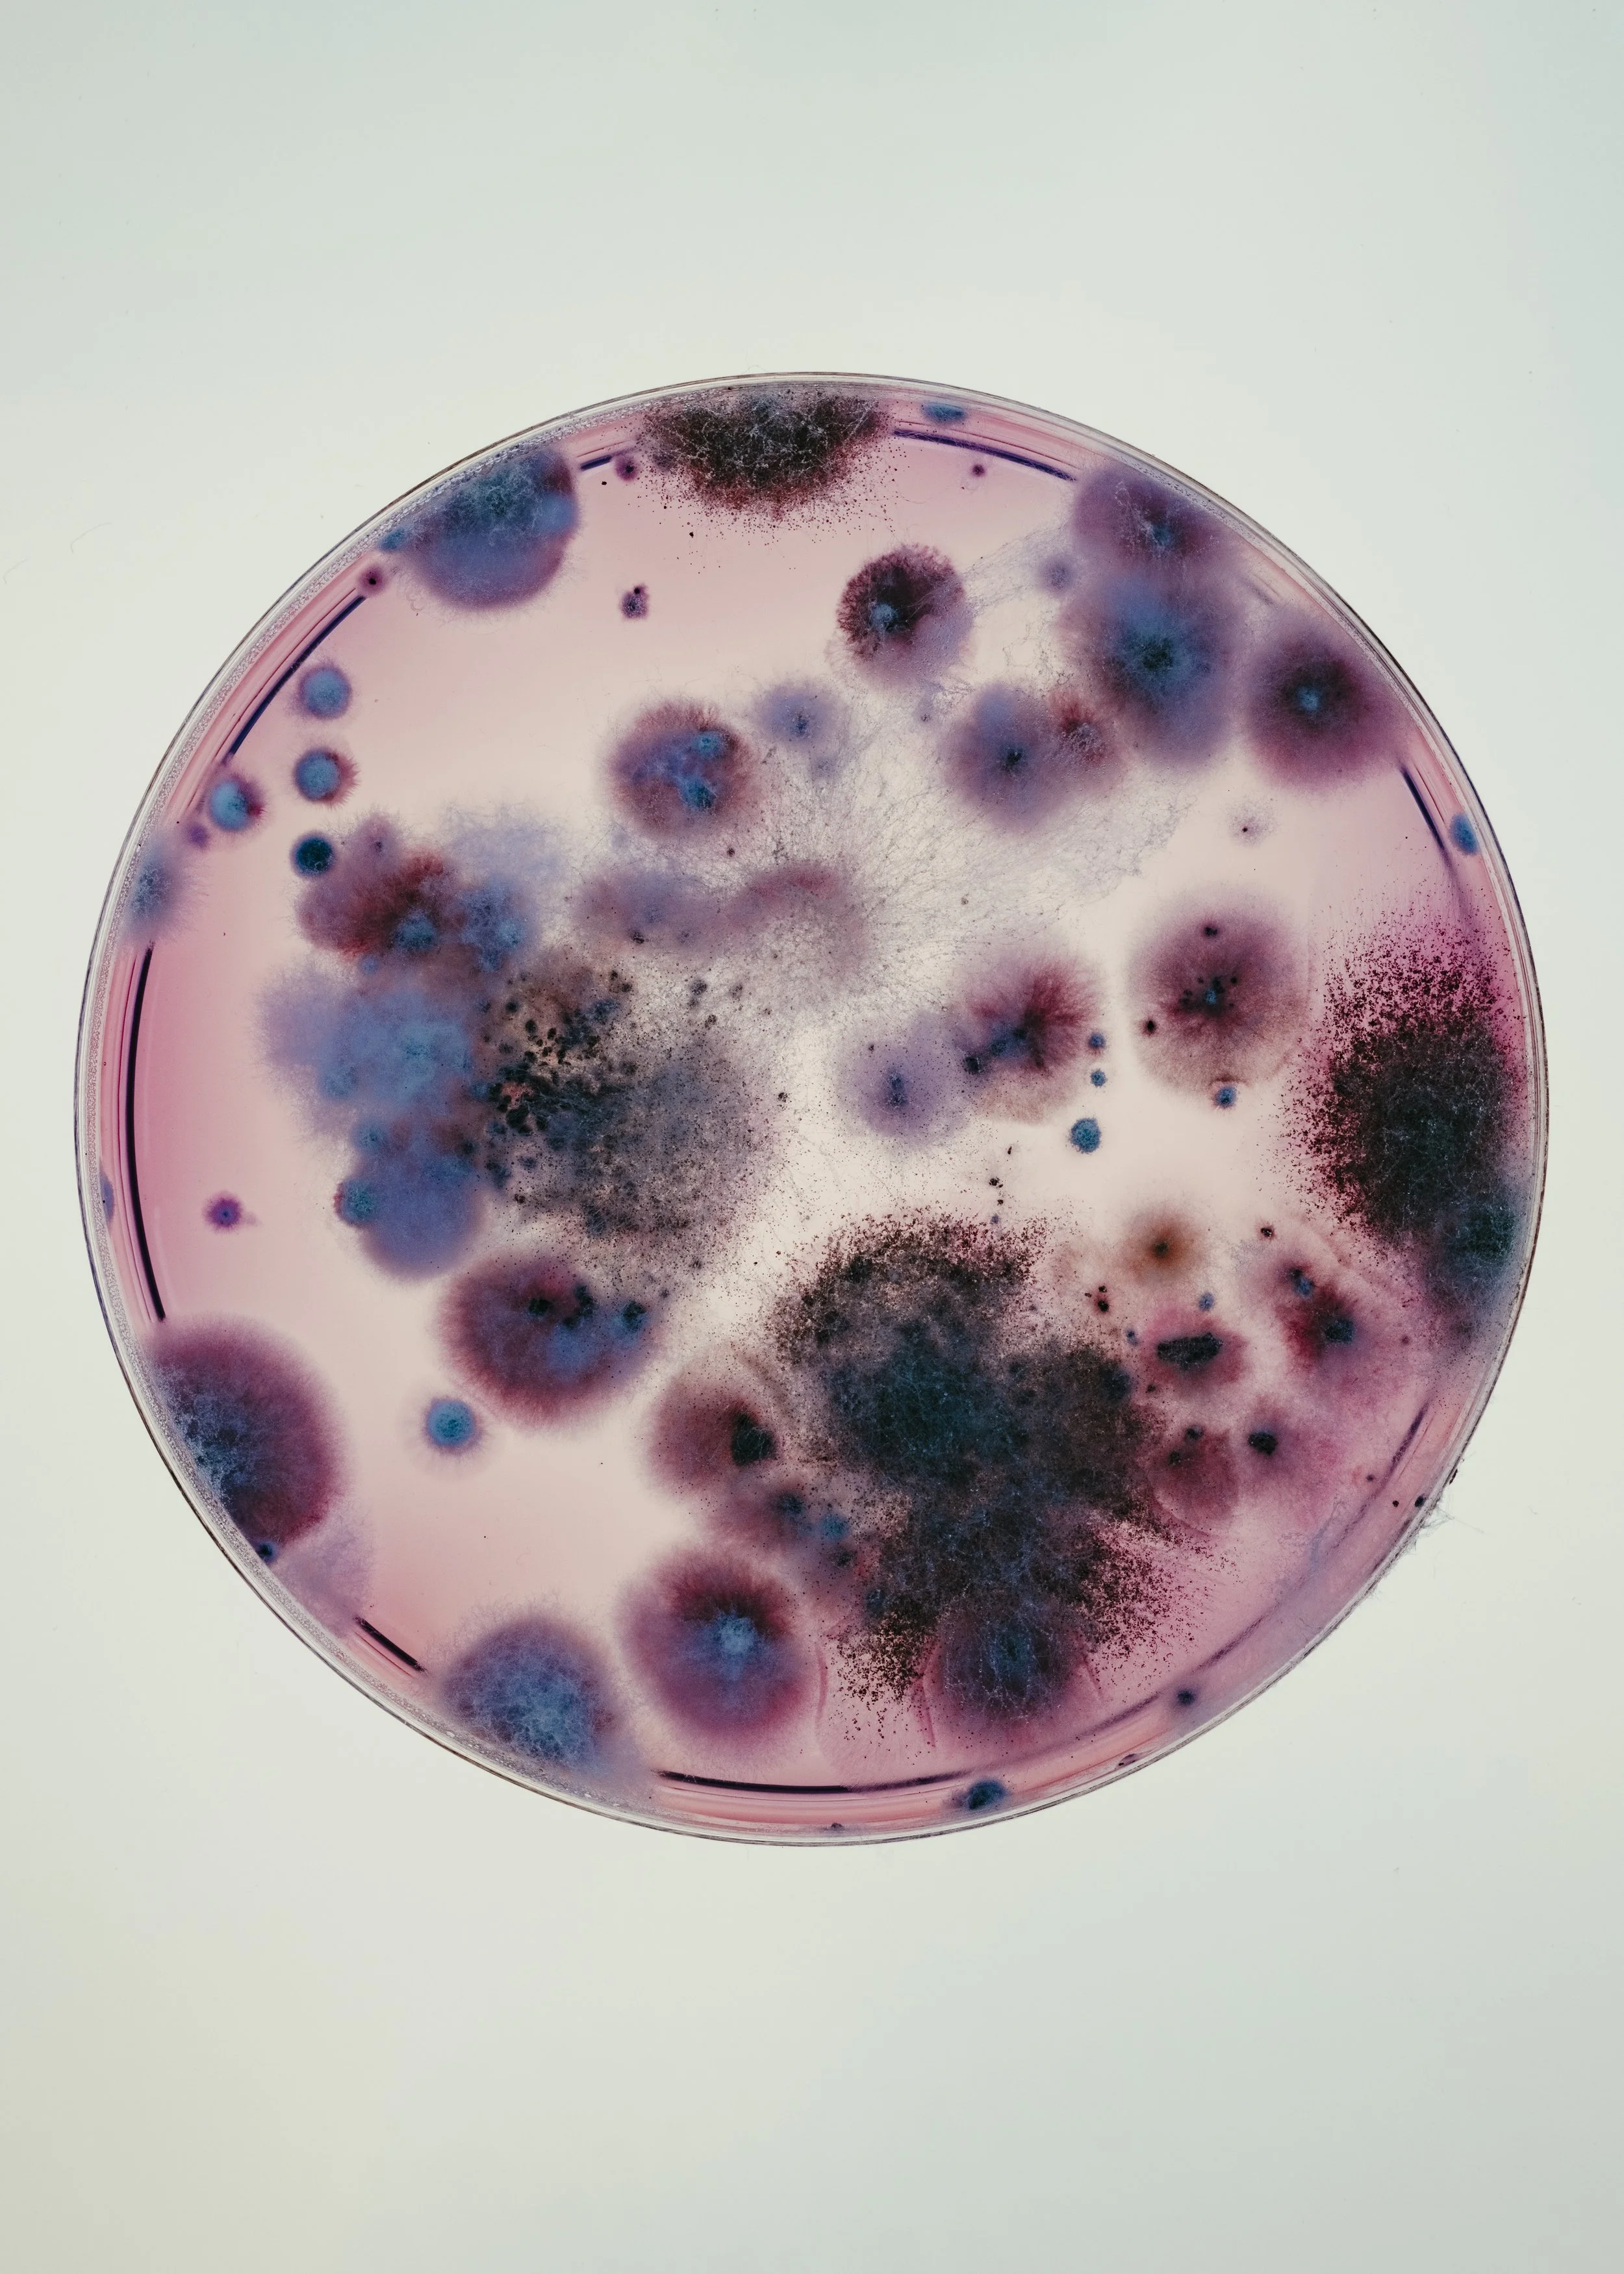

12 invisibles
It’s a project we made together with dear friend and magician of analog photography Petras Saulenas, Spartakas Petrovas - former head of GVT (hazardous waste management company), wonderful scientist from Natures Research Centre Laboratory of Biodeterioration Algimantas Paskevicius and crew.
Company named GVT cleans soil from old kinds of hazardous waste. And they do it using microorganisms. To be more precise - some kind of fungi and bacteria cocktails. These tiny fellas litteraly eat toxic waste and clean soil. I was amazed by such idea. Yes it’s slow - but it is groundbreaking. Or to be exact - groundcleaning. Implications of this are enormous, yet it seemed this company was not very well known. Especially these super microorganisms. So we wanted to show what is “invisible”. They use 12 different cocktails, so we took them and looked at those Petri dishes through microscope for four days. Oh and we witnessed all kinds of wonders. This is a story about unsung heroes. They are everywhere - inside our bodies (our maybe our bodies are inside them), in the oceans and in the soil. They are superpower and we only scratched the surface.
As in heaven so on earth. Microorganisms create living landscapes, structures which resemble web of galaxies. Nature performing never ending Sufi dance of metamorphosis (goes nicely with Jóhann Jóhannssons Drone Mass).Each Petri dish as a planet in cosmos. Couple of examples how nutrient medium becomes something spontaneously magnificent.